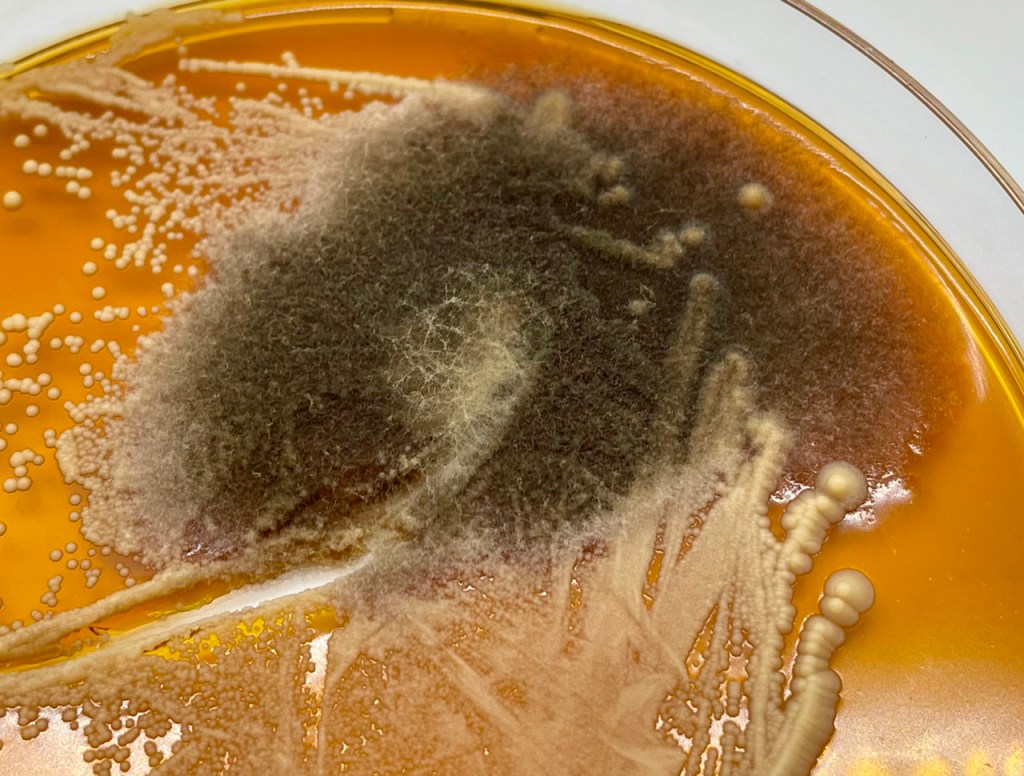
Yeast versus Mold: Yeast is the smooth white and mold is the fuzzy green/black

Bucket with Film Yeast
Yeast versus Mold: Yeast is the smooth white and mold is the fuzzy green/black 
Mold on top of Cider
If you’ve read many of my articles, you know I often answer questions with “it depends”. However, that doesn’t mean we can’t define practices that are generally helpful and will not create problems when making hard cider. We can call these good practices or rules. Following these rules will help prevent problems during your cider making process. Can you break these rules and make great cider? I’m sure you can. However, following these rules will never cause you to make a bad cider. One of these rules is around exposure to oxygen and it’s a really simple rule.
Avoid exposing your juice and cider to oxygen.
I could leave it at that and this could be my shortest article ever. But, that would not be in my style, so let’s explore why oxygen generally doesn’t help the cider making process, and why you should avoid exposing your juice and cider to it.
The Impact to Juice
Oxygen is needed by yeast to help them survive stressful environments, but it will generally enable more harmful reactions than beneficial ones. When oxygen is exposed to juice prior to the start of fermentation, it enables the following.
- Acetic Acid Production: Acetic acid bacteria requires oxygen to reproduce and if yeast are not fermenting, acetic acid bacteria can start using the oxygen and nutrients in juice to reproduce. This creates acetic acid, which is undesirable. The best way to prevent this is to ensure fermentation starts quickly, which is best done by inoculating with yeast.
- Phenolic Oxidation: Many phenolic compounds are easily oxidized. You experience this when the juice and pomace turns brown, but oxygen can also reduce non-browning phenolics. Whether you see oxidative browning or not, you are losing phenolic compounds when your juice is exposed to oxygen. Initially, it can appear that you gain color as your juice will turn amber or brown, but this color is usually lost during fermentation. For example, oxygenate Granny Smith juice and the pale greenish juice will turn amber. Ferment that amber juice and it will be almost clear once the fermentation completes. Macerating pomace helps extract phenolic compounds, but it also enables the loss of phenolic compounds because the pomace has access to oxygen and often browns. Phenolic oxidation and oxidative browning are not generally beneficial.
- Undesirable Aromas: Oxygen, often from a large headspace or dissolved in the juice during processing can allow mold and bacteria growth. The risk is greatest when fermentation is delayed. Solids floating on top of the juice can allow mold to grow and film yeast can form yeast rafts on the surface. These organism usually create undesirable aromas and in the case of mold, can even create toxins. However, this only occurs if there is oxygen present. That is why you want fermentation to start quickly. Fermentation produces CO2, which displaces the oxygen and provides a protective shield as it is heavier than oxygen. Note that fermentation can be delayed if you add too much sulfite (Campden), the juice is too cold, or no dominate yeast colony forms.
The Impact to Cider
Once fermentation completes, you have cider versus juice. That doesn’t make it less prone to oxygen exposure. The yeast no longer produce CO2, which means oxygen can start entering the headspace. Also, racking or processing the cider will usually add small amounts of oxygen to the cider. Unless you are using kegs or similar containers with an inert gas like CO2, your hard cider can start being exposed to oxygen and you now face the following.
- Acetic Acid Production: With fermentation completes, no CO2 is produced to protect your cider. Your cider is susceptible to acetic acid bacteria growth if you are allowing oxygen to enter the headspace. It generally isn’t enough to make vinegar but the volatile acidity can reach undesirable levels if you allow cider to have access to oxygen. Eliminating headspace and even adding some juice or sugar can help remove the oxygen as fermentation starts up again, pushing out the oxygen and creating a layer of CO2. Note that sulfite (Campden) doesn’t protect you against this condition. Acetic acid bacteria can live with free SO2 present and sulfites don’t bind oxygen effectively, they bind with phenolics.
- Phenolic Oxidation: You want to encourage polymerization or condensing of tannins during aging versus oxidation. The oxidizing process removes tannins and color (anthocyanins). A anaerobic environment will minimize oxidation and permit the positive polymerization process. I recognize that just like yeast can benefit from some oxygen prior to fermentation, the aging process can benefit from micro oxygenation. This is most commonly found from aging in wooden barrels or in bottles with corks. This represents a couple milligrams per liter of oxygen over months, so sticking to the rule on avoiding oxygen will minimize the risks without negatively impacting the results.
- Undesirable Aromas: A large headspace with a large amount of surface area is an even bigger risk for cider than juice. The two most common organisms in an aerobic environment are mold and film yeast. The difference is that cider lacks the potential of the fermentation process and the protective generation of CO2. Buckets are notorious for allowing oxygen exposure, which is why the rule of avoiding oxygen could age restated as never store cider in a bucket. Just like juice, you are encouraging the creation of vegetal, musty, and other undesirable aromas. Mold growth also creates the risk of toxins being created. Since sulfites don’t stop these organisms, the answer is to limit oxygen by limiting headspace or using inert gases, like CO2, in the headspace.
Check out some other interesting articles by Prickly Cider.
Don’t miss any future Mālus Trivium articles. Follow me and you will get a link to my latest article delivered to your inbox. It’s that easy!
As a brewer it is critical that yeast have a very healthy amount of oxygen in order to promote a complete fermentation process, converting the sugars into alcohol and CO2. Thus it is critical to ensure wort is well oxygenated.
I would assume the same for cider, but you mention keeping O2 out of the juice – Is there something in apple juice that provides an abundance of O2, thus no need to ensure juice is oxygenated? Agree that once fermentation has started you want to keep O2 out of the process.
LikeLike
Remember that I said there are always exceptions. Theoretically, oxygen at the start should be lower risk. However, cider is different from beer in that you have to extract the juice from the apple. This process will add a lot of oxygen, in fact is can add to much as it can remove the phenolics. Also, many use wild yeast for fermentation so having a lot of oxygen in the juice or in the headspace and using wild yeast can be a slow fermentation process. This can result in acetic acid development and mold as the yeast biomass is slow to build as they compete. Inoculating will help eliminate that and your inoculated yeast are usually robust already. Unlike wine, the risk of a stalled fermentation is low and often desirable with cider so trying to make the yeast as strong as possible is often not as desirable.
LikeLike
Thanks for expanding. The oxygenation of the juice in the press makes sense and of course differentiates from the mash process in brewing.
LikeLike
Mark,
Since cider is lacking in longer chain sugars (besides sucrose), the oxygen requirement is basically zilch. The primary affect of oxygen on attenuation in brewing is to increase the synthesis of sterols in the yeast membrane. They need these to operate the machinery that transports sugars like maltotriose across the cell membrane.
Stuck cider fermentation can somewhat rarely be revived by oxygen, the usual fix is a simple nitrogen source like DAP.
Here’s a paper showing how the oxygen requirement of yeast is mitigated by sterol content of must, or supplementation. https://pubmed.ncbi.nlm.nih.gov/15666147/
LikeLike